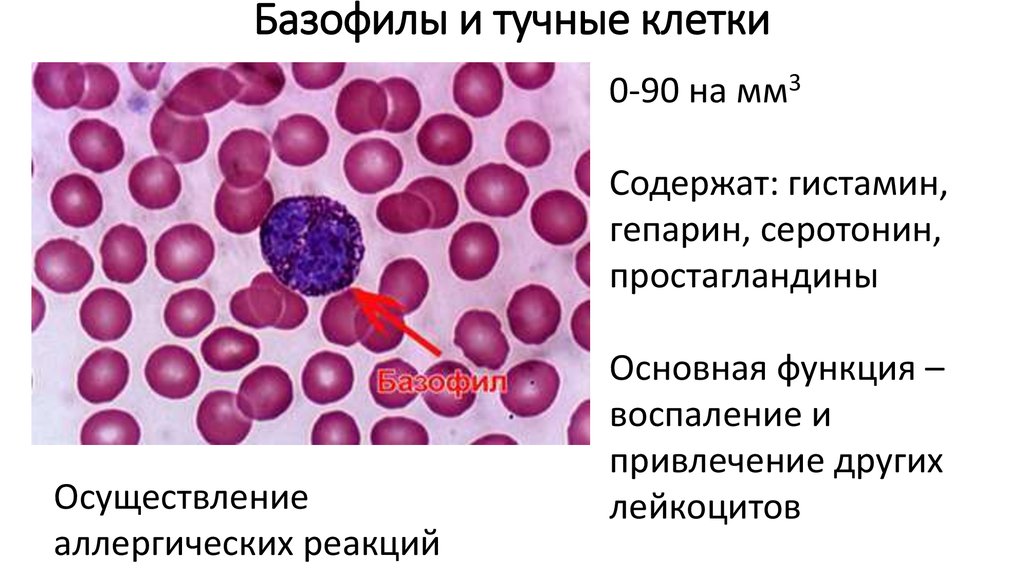

Похожие презентации:
Иммунная система
1. Иммунная система
2.
ИммунитетСпособность организма освобождаться от чужеродных
объектов
3.
Главный комплекс гистосовместимости (MHC)МНС – белки, присутствующие на поверхности всех клеток
Презентуют (предъявляют) кусочки белков
МНС I – присутствуют на всех ядерных клетках организма и
презентуют кусочки белков, находящихся в этих клетках
МНС II – присутствуют только на некоторых клетках иммунной
системы и презентуют участки чужеродных белков
4. Лейкоциты
5.
ЛейкоцитыБелые кровяные тельца
Истинные клетки крови
-
активно передвигаются
способны к хемотаксису
покидают кровяное русло
поглощают крупные
объекты путем фагоцитоза
6.
лейкоцитыгранулоциты
эозинофилы
агранулоциты
базофилы
нейтрофилы
Тучные клетки
лимфоциты
моноциты
макрофаги
7.
Гранулоциты8.
Эозинофилы120-350 на мм3
Являются микрофагами
(потому что основная роль
не в этом)
Основная функция –
антипаразитарный
иммунитет
9.
10.
Базофилы и тучные клетки0-90 на мм3
Содержат: гистамин,
гепарин, серотонин,
простагландины
Осуществление
аллергических реакций
Основная функция –
воспаление и
привлечение других
лейкоцитов
11.
Нейтрофилы4000-9000 на мм3
Основная функция –
уничтожение патогенов
Эффективные фагоциты
Погибшие нейтрофилы
образуют гной
Гранулы:
1) Гидролазы,
пироксидазы, лизоцим
2) дефензины
12.
13.
Нетоз у нейтрофилов14.
МоноцитыПримерно 450-600 на мм3
Крупные, много лизосом
2-3 дня циркулируют в крови,
потом выходят в ткани и
превращаются в макрофагов
Кроме того, в тканях есть
собственные макрофаги
Основная функция –
поглощение патогенов и
презентация антигенов
15.
Презентация антигена16.
лимфоцитыТ-лимфоциты
В-лимфоциты
Натуральные
киллеры (NK)
Т-киллеры
Т-супрессоры
Т-хэлперы
Плазменные
клетки
Клетки памяти
Первого типа
Второго типа
17.
NK18.
B-лимфоциты19.
20.
гуморальныйклеточный
неспецифический
специфический
Неспецифический
гуморальный
Специфический
гуморальный
Неспецифический
клеточный
Специфический
клеточный
21.
Неспецифический гуморальный1.
2.
3.
4.
Лизоцим
Интерфероны
С-реактивный белок
Система комплемента
22.
Неспецифический клеточныйНейтрофилы
Моноциты и макрофаги
NK-лимфоциты
Базофилы
Эозинофилы
23.
Специфический клеточныйЕсли антиген в комплексе с МНС I, то активируются Ткиллеры
Если антиген в комплексе с МНС II, то активируются Тхелперы.
24.
Специфический гуморальныйВ-лимфоциты производят антитела. Сначала класса Ig
M, потом класса IgG.
Антитела метят антигены, а в случае Ig M еще и
склеивают их.
25.
Связь специфического и неспецифическогоиммунитета
Тх -1 активируют макрофагов
Комплекс антиген-антитело привлекает макрофагов,
улучшает прикрепление белков системы
комплемента
26.
27.
28.
ИммунодефицитыВрожденные
- Неправильные лимфоциты (например синдром Вискотта – Олдрича)
- Нет рекомбинации
- Нет переключания с синтеза IgD на другие типы антител
- Недоразвитие лимфоидных органов (например, синдром ДиДжорджи
Приобретённые
- Нехватка витаминов
- Паразиты
- ВИЧ
29.
Гиперчувствительность (аллергия)I тип – немедленного типа
II тип – на клетки с антигенными свойствами
III тип – осаждение комплексов антиген-антитело
IV тип – на измененные белки клеток
Холодовая аллергия
Криоглобулинемия

Медицина
Медицина








